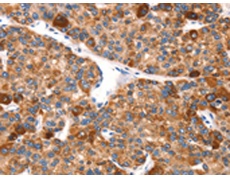
一抗

|
Background: |
This gene is a member of the EPO/TPO family and encodes a secreted, glycosylated cytokine composed of four alpha helical bundles. The protein is found in the plasma and regulates red cell production by promoting erythroid differentiation and initiating hemoglobin synthesis. This protein also has neuroprotective activity against a variety of potential brain injuries and antiapoptotic functions in several tissue types. |
|
Applications: |
ELISA, IHC |
|
Name of antibody: |
EPO |
|
Immunogen: |
Synthetic peptide of human EPO |
|
Full name: |
erythropoietin |
|
Synonyms: |
EP; MVCD2 |
|
SwissProt: |
P01588 |
|
ELISA Recommended dilution: |
1000-2000 |
|
IHC positive control: |
Human liver cancer and Human thyroid cancer |
|
IHC Recommend dilution: |
25-100 |

 購(gòu)物車
購(gòu)物車 幫助
幫助
 021-54845833/15800441009
021-54845833/15800441009